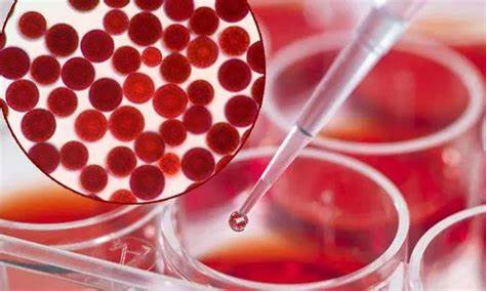
图片

近日,科伦药业75岁董事长刘革新赤膊代言,展示健硕肌肉,亲自代言了自家的麦角硫因产品,引发全网热议。
麦角硫因是一种天然的含硫氨基酸,存在于动植物和微生物体内,具有抗氧化、抗炎、免疫调节等多种功能。
此前,受限于极高的生产成本,麦角硫因难以被广泛应用,而合成生物技术的应用使得麦角硫因价格明显下降,一公斤的价格也从此前的几十万降至目前的万元左右。
麦角硫因爆火再次引爆了资本对合成生物学技术的关注,5月15日,合成生物概念股集体走高,科伦药业子公司川宁生物迎来“20CM”涨停,芭薇股份、拓新药业、金达威、欧康医药、蔚蓝生物等企业跟涨。
根据麦肯锡研究,生物制造有望替代全球60%以上的物质生产方式,覆盖70%化学法生产的化合物,预计将在未来10到20年对全球产生每年2万亿美元的直接经济影响。
近年来,利用合成生物学制备美妆、食品、医药等领域的关键成分已成为重要趋势,一批具有突破性的生物活性成分正加速产业化进程,为行业带来巨大变革。
最强抗氧化剂—虾青素
虾青素又名虾红素,是一种天然类胡萝卜素,于1939年在虾中发现,是目前自然界发现的最强天然抗氧化剂。
在食品领域,虾青素粉作为天然食品添加剂,能够以着色剂、抗氧化剂能添加到饮料、肉类、烘焙中,此外虾青素还是功能性食品,提高人体免疫力和抗氧化能力。
化妆品领域,虾青素能够为产品提供独特的颜色,并且具有很好的稳定性,良好的抗氧化能力有助于保护皮肤免受自由基的损害。
水产养殖方面,虾青素也被认为是优质的饲养原料,喂养能显著提高鱼虾蟹的亩产量、成活率、免疫力,减少养殖病率,且肉质更加鲜美。
虾青素的主要来源于虾壳、蟹壳、红球藻等,但提取过程非常困难,成本奇高。而生物发酵法则能够降低养殖成本,提高虾青素产量。
国内包括嘉必优、元育生物、元一生物、微研生物等公司都在布局该领域,其中元一生物已经成功合成全左旋游离态虾青素,已布局4000吨产能。
奶粉革命——母乳低聚糖(HMOs)
母乳低聚糖(HMOs)是母乳中含量仅次于乳糖和脂肪的第三大固体成分,占到母乳总碳水化合物含量的20%,是不可忽略的营养物质。

目前,HMOs有超过 200种 不同的结构,具有较强的差异化,在肠道健康与促进代谢,调节免疫功能与抗感染、促进眼脑发育等发挥重要作用。
随着我国允许HMOs添加进奶粉的相关政策颁布,HMOs近年在配方奶中爆火,普遍加入高端奶粉中。
因此HMOs是不少合成生物企业重点布局领域,其中已获批的2'-岩藻糖基乳糖(2'-FL)和乳糖-N-新四糖 (LNnT) 前景最为广阔。
上市龙头嘉必优其2'-FL已获批准,中试产能可达200-300吨,还可根据市场需求配置共线生产,灵活调整产能配比,3-FL、3'-SL 和 6'-SL 已进入中试。
除此之外,由蒙牛与弈柯莱生物共同孵化的虹摹生物布局了2'-岩藻糖基乳糖(2'-FL)300t/a的生产规模。
朗坤环境旗下的朗健生物已经布局年产1000吨HMO项目,包括,一期工程包括260t/a(乳糖-N-四糖(LNT)130t/a、乳糖-N-新四糖(LNnT)130t/a。
山东恒鲁生物已经实现乳糖-N-三糖(LNnT的前体)的大规模量产以及高纯度结晶,即将产业化落地。此外,一兮生物、芝诺科技也是该赛道值得关注的企业。
最完美的蔗糖替代者——D-阿洛酮糖
D-阿洛酮糖是一种自然界中存在但含量极少的一类单糖,其甜度为蔗糖的70%,但热量仅为蔗糖的0.3%,具有热量低、稳定性高、无吸湿性等优点。
因具有与蔗糖极为相近的口感及容积特性,D-阿洛酮糖成为当下最为理想的蔗糖替代品,市场前景广阔。

近年来美国、日本、韩国、新加坡、墨西哥、智利等多个国家已经批准D-阿洛酮糖在食品中的应用。
国家卫健委于2024年5月发布公告,将“d-阿洛酮糖-3-差向异构酶”被列入食品工业用酶制剂新品种,被视为D-阿洛酮糖将在国内获批的重要信号。
目前,D-阿洛酮糖的现价约在3万元/吨,生物合成已成为主流方法,随着合成生物学推动效率的进一步提高,其未来价格有望降至1万元/吨左右,极大拓宽下游应用场景。
据统计,2023年全球D-阿洛酮糖市场规模达到了1.73亿美元,预计2030年将达到5.44亿美元,届时我国D-阿洛酮糖市场规模也将超过1亿美元。
当前全球主要生产厂商包括日本松谷(Matustani Chemical)、英国泰莱(Tate&lyle)、韩国三养(Samyang)、百龙创园、保龄宝等少数几家企业,三元生物、金达威、微元合成等多家公司正在加速扩张产能。
接棒玻尿酸的下一个王者——重组胶原蛋白
胶原蛋白为人体内重要的结构蛋白,参与人体组织器官的再生及修复,约占人体蛋白质总含量的30-40%,随年龄逐渐流失。
不同于动物源胶原蛋白,重组胶原蛋白利用基因工程技术通过宿主细胞(大肠杆菌、酵母等)制备,具有安全性好、加工性强、质量稳定、生物活性高等优点。
目前,重组胶原蛋白被广泛应用于专业皮肤护理与医美领域中,在医用生物耗材及食品领域也有应用。

近年来,合成生物学的快速发展,推动了重组胶原蛋白的工业化生产进程。
2006年,中国企业在国际上首次实现了重组胶原蛋白发酵规模吨级突破,迈出了重组胶原蛋白规模化生产的关键一步。
2011年之后,重组胶原蛋白产品注册证相继获批,市场规模快速增长。
数据显示,2017-2021 年重组胶原蛋白市场规模以63%的复合增速增至108亿元,这一增速远高于动物源性胶原蛋白、玻色因、A醇、胜肽等其他原料。
到2021年,超过15%的皮肤护理产品、超过8%的院线产品,选择以重组胶原蛋白作为主要原料。
随着重组胶原蛋白在行业渗透率的进一步提升,这一原料将仍保持高速增长态势,预计2027年市场规模有望达到1083亿元。
作为高壁垒赛道,重组胶原蛋白行业集中度非常高,目前国内能够大规模批量生产的主要为巨子生物、锦波生物、创健医疗和聚源生物等企业。